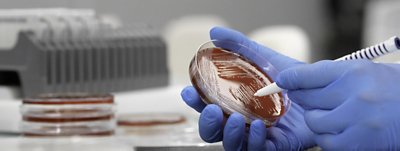

Souches calibrées BIOBALL®
PRENEZ LE CONTRÔLE DE VOTRE CONTRÔLE QUALITÉ MICROBIOLOGIQUE
BIOBALL® délivre une exactitude et une précision sans précédent, lot après lot.
Un petit matériau de référence certifié lyophilisé hydrosoluble contenant un nombre précis de micro-organismes viables pour le contrôle qualité quantitatif.


- Souches calibrées BIOBALL
- Souches calibrées BIOBALL
- Contrôle qualité microbiologique
- Présentation
- Technologie
- Services et assistance
- Ressources
Matériau de référence certifié pour le contrôle qualité microbiologique
BIOBALL® utilise une technologie de cytométrie exclusive pour produire un matériau de référence certifié précis et exact pour le contrôle qualité microbiologique.
- Test de stimulation de croissance
- Validation de la méthode
- Test d'efficacité antimicrobienne
- Isolat interne GPT (Growth Promotion Testing, test de stimulation de croissance)
- Contrôles quotidiens
- Test de remplissage aseptique
BIOBALL® offre des solutions pour un large éventail de tests de contrôle qualité aussi bien pour le secteur agro-alimentaire que pour le secteur pharmaceutique.
BIOBALL® utilise une technologie de cytométrie exclusive et intellectuelle pour produire un matériau de référence certifié précis et exact pour le contrôle qualité microbiologique.
Télécharger le guide de souches disponibles
- Nom de fichier
- BIOBALL PHARMA - Available Strains Iss 88.pdf
- Taille
- 377 KB
- Format
- application/pdf
Caractéristiques
- Exactitude & Précision – chaque lot, chaque aliquote
- Matériaux de référence certifiés ISO:17034
- Rentable – Avec des solutions de gain de temps
- Efficace – Flux de travail simple et rapide
- ProduitMULTISHOT stable jusqu’à 14 jours
- Test « prêt à l’emploi » disponible à tout moment sans décongélation nécessaire
- Réduit les temps de préparation, facile à utiliser, en 4 étapes seulement
- Traitement des données numériques
Pour accéder aux certificats d’analyse et aux modes d’emploi pour les produits BIOBALL®, veuillez consulter notre Centre de ressources.
La souche qui vous intéresse dans le format UFC de votre choix
BIOBALL® Custom Services, conserve et fabrique vos isolats internes et autres souches microbiennes qui vous intéressent dans un format BIOBALL® prêt-à-l’emploi. Chaque année, BIOBALL® Custom Services travaille avec un grand nombre d’isolats internes provenant de différentes origines géographiques, et les personnalise sous la forme d’une BIOBALL exacte et précise, qui répond aux besoins spécifiques en termes de test de contrôle qualité des fabricants pharmaceutiques.
Assistance
- Isolat interne au format BIOBALL®
- Custom Services pour répondre à vos besoins spécifiques
- Soutien à la certification et accréditations
Téléchargements
BROCHURE - Créer de la valeur en exploitant pleinement le potentiel de vos essais de biotransformation
Découvrez notre gamme complète
- Nom de fichier
- BMX_Bioproduction_Brochure_A4_vF_web.pdf
- Taille
- 15 MB
- Format
- application/pdf
Brochure - BIOBALL®
Téléchargement
- Nom de fichier
- BROCHURE_BIOBALL_A4_05_23_9324107_Pages.pdf
- Taille
- 2 MB
- Format
- application/pdf
Brochure - BIOBALL® - GPT de milieux sélectifs
Téléchargement
- Nom de fichier
- BROCHURE_BIOBALL_GPT_A4_05_23_9324105_Pages.pdf
- Taille
- 1 MB
- Format
- application/pdf
Brochure - BIOBALL® - Services isolats internes
Téléchargement
- Nom de fichier
- BROCHURE_BIOBALL_INHOUSEISOLATE_A4_05_23_9324047_Pages.pdf
- Taille
- 2 MB
- Format
- application/pdf
Brochure - BIOBALL® - Burkholderia Cepacia Complex
Souches disponibles Iss 90 - BIOBALL®
Téléchargement
- Nom de fichier
- Available-Strains-Iss-90.pdf
- Taille
- 356 KB
- Format
- application/pdf
Connaissances
Poster - Les matériaux de référence microbiologiques correspondent-ils à leurs "certificats d’analyse" associés ?
Téléchargement
- Nom de fichier
- BIOBALL - Competitor Study Brochure 1pge 2018.pdf
- Taille
- 230 KB
- Format
- application/pdf
Poster - Redéfinir le contrôle qualité microbiologique quantitatif
Téléchargement
- Nom de fichier
- BIOMERIEUX-BIOBALL-Redefining-Quantitative-Microbiological-Quality-Contr....pdf
- Taille
- 850 KB
- Format
- application/pdf
Poster - Test de stimulation de croissance pour une surveillance environnementale